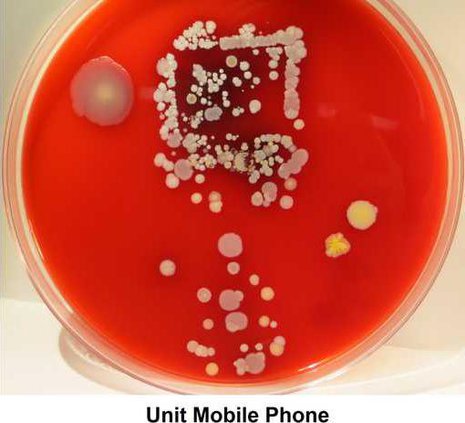
74bea6f3593a0f21229a142306bf1f7bbcd6572333be79ad6317b5fe0b5ee160

Want your kids to wash their hands? Gross them out, say researchers at Henry Ford Hospital in Detroit.
A report they presented last week at the annual conference of the Association for Professionals in Infection Control and Epidemiology showed that health-care workers were more likely to wash their hands after they viewed magnified pictures of bacteria swarming on skin and work surfaces.
Co-authors Ashley Gregory and Eman Chami call it "the yuck factor." After inspecting images of bacteria on a persons hand, a cellphone and a mouse pad, workers in four patient-care units improved their hand-washing by an average of 24 percent, and in some cases, much more than that.
Presumably, health-care workers are already well-educated about the need to wash their hands regularly since weve known that disease is transmitted through dirty hands since 1846, when a Hungarian doctor realized that women were dying in childbirth because of shared germs. (Unfortunately, for the largely forgotten Ignaz Semmelweis, French chemist Louis Pasteur got most of the credit for germ theory.)
As much as we'd like to believe hospitals are the cleanest public places, the Centers for Disease Control and Prevention say health-care workers clean their hands only half as much as they should, which explains why 1 in 25 hospital patients picks up an infection from the place they went to get well.
Enter the team at Henry Ford Hospital, which is determined to improve sanitation. According to the news site Vocativ, Gregory and Chami swabbed nurses' hands and equipment, then showed them what they found under a microscope.
"The nurses were horrified. But they started washing their hands," wrote Joshua A. Krisch for Vocativ. Afterward, one unit increased its compliance by 142 percent.
I think health-care workers, in general, become numb to the fact that hospitals are an environment of germs, Gregory said. Pictures go a long way to breaking that detachment and give hospitals a new tool for their hand-hygiene toolkit.
It's a tool that parents can use as well.
Hospital workers are supposed to wash their hands 100 times in a 12-hour shift. A parent's bar is not so high, but the CDC says people should wash their hands before and/or after nine activities: preparing food, eating, caring for the sick, treating a wound, changing diapers, using the bathroom, blowing your nose, dealing with animals and touching garbage.
Of course, some experts say today's children are too clean, and we're sanitizing them so much that their immune systems aren't functioning properly. The Washington Post has noted that children ages 6 to 11 only need to bathe once or twice a week, unless they've been playing in mud, swimming in a pool, ocean or lake, or are just exceptionally smelly.
But pretty much everyone agrees that vigorous hand-washing with soap and water is important. And given the research from Detroit, parents might want to consider posting a picture of some creepy-crawly bacteria above the sink. (No, they cannot keep them as pets.)
A report they presented last week at the annual conference of the Association for Professionals in Infection Control and Epidemiology showed that health-care workers were more likely to wash their hands after they viewed magnified pictures of bacteria swarming on skin and work surfaces.
Co-authors Ashley Gregory and Eman Chami call it "the yuck factor." After inspecting images of bacteria on a persons hand, a cellphone and a mouse pad, workers in four patient-care units improved their hand-washing by an average of 24 percent, and in some cases, much more than that.
Presumably, health-care workers are already well-educated about the need to wash their hands regularly since weve known that disease is transmitted through dirty hands since 1846, when a Hungarian doctor realized that women were dying in childbirth because of shared germs. (Unfortunately, for the largely forgotten Ignaz Semmelweis, French chemist Louis Pasteur got most of the credit for germ theory.)
As much as we'd like to believe hospitals are the cleanest public places, the Centers for Disease Control and Prevention say health-care workers clean their hands only half as much as they should, which explains why 1 in 25 hospital patients picks up an infection from the place they went to get well.
Enter the team at Henry Ford Hospital, which is determined to improve sanitation. According to the news site Vocativ, Gregory and Chami swabbed nurses' hands and equipment, then showed them what they found under a microscope.
"The nurses were horrified. But they started washing their hands," wrote Joshua A. Krisch for Vocativ. Afterward, one unit increased its compliance by 142 percent.
I think health-care workers, in general, become numb to the fact that hospitals are an environment of germs, Gregory said. Pictures go a long way to breaking that detachment and give hospitals a new tool for their hand-hygiene toolkit.
It's a tool that parents can use as well.
Hospital workers are supposed to wash their hands 100 times in a 12-hour shift. A parent's bar is not so high, but the CDC says people should wash their hands before and/or after nine activities: preparing food, eating, caring for the sick, treating a wound, changing diapers, using the bathroom, blowing your nose, dealing with animals and touching garbage.
Of course, some experts say today's children are too clean, and we're sanitizing them so much that their immune systems aren't functioning properly. The Washington Post has noted that children ages 6 to 11 only need to bathe once or twice a week, unless they've been playing in mud, swimming in a pool, ocean or lake, or are just exceptionally smelly.
But pretty much everyone agrees that vigorous hand-washing with soap and water is important. And given the research from Detroit, parents might want to consider posting a picture of some creepy-crawly bacteria above the sink. (No, they cannot keep them as pets.)